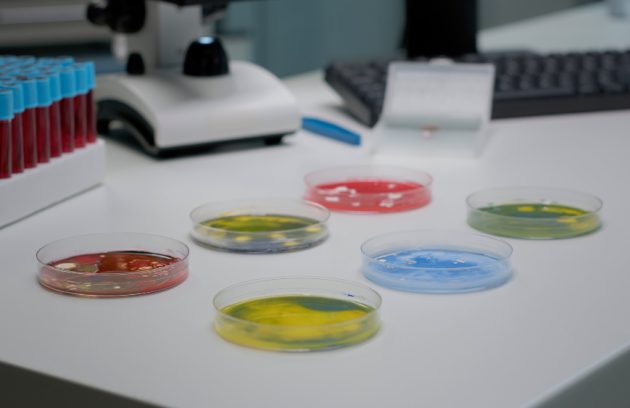

Contactez-Nous Contactez-nous
Contactez-Nous Contactez-nous LABORATOIRE D'ANALYSES
MEDICALES
Laboratoire Marrakech
Labovie Marrakech
Laboratoire d'analyses
 Contactez-Nous Contactez-nous
Contactez-Nous Contactez-nous LABORATOIRE D'ANALYSES
MEDICALES
Laboratoire Marrakech
Labovie Marrakech
Laboratoire d'analyses
 Contactez-Nous Contactez-nous
Contactez-Nous Contactez-nous LABORATOIRE D'ANALYSES
MEDICALES
Laboratoire Marrakech
Labovie Marrakech
Laboratoire d'analyses
Choisissez notre laboratoire,
choisissez l'analyse
la plus précise pour vous
Depuis 2022, nos patients nous font confiance pour pratiquer leurs examens au sein de notre centre de prélèvement. Nous effectuons ainsi leurs analyses dans plusieurs disciplines : Microbiologie, Biochimie, Hématologie, Hémostase, Immunologie, Hormonologie, Marqueurs tumoraux, Sérologies…

Labovie Marrakech
الدكتورة علالي أسماء

Hors horaires : numéro d’urgence disponible: +212 (0)705675125
- Lundi :
- 07:30 - 22:30
- Mardi :
- 07:30 - 22:30
- Mercredi :
- 07:30 - 22:30
- Jeudi :
- 07:30 - 22:30
- Vendredi:
- 07:30 - 22:30
- Samedi :
- 07:30 - 22:30
- Dimanche
- 07:30 - 22:30
Nos Services
Découvrez l’ensemble des examens et analyses réalisés au Laboratoire LABOVIE, grâce à un plateau technique moderne et une expertise médicale reconnue. Nous proposons des prestations complètes allant du bilan général aux analyses spécialisées de fertilité, génétique, hormonologie et biologie moléculaire.

Autres examens spécialisés
LABOVIE réalise également : Test de dépistage du cancer du col (HPV) Examen cytogénétique (caryotype)…
Détail
Dépistage HPV – Cancer du col
Test HPV haute sensibilité permettant de détecter les souches à haut risque : Dépistage recommandé…
Détail
Marqueurs tumoraux
Analyses sanguines permettant le suivi ou le dépistage de certains cancers : PSA (prostate) CEA…
Détail
Bilan de fertilité féminine
Un ensemble d’analyses permettant d’évaluer la capacité reproductive de la femme : Dosages hormonaux (AMH,…
Détail
Bilan de fertilité masculine
Analyses complètes de la qualité spermatique : Spermogramme Test de Migration-Survie (TMS) Fragmentation de l’ADN…
Détail
Insémination intra-utérine – Préparation spermatique
Le laboratoire prépare et optimise l’échantillon spermatique pour les procédures d’IIU : Tri des spermatozoïdes…
Détail
Hormonologie
Dosages hormonaux permettant d’évaluer : Thyroïde Fertilité féminine et masculine Métabolisme (cortisol, ACTH…) Hormones de…
Détail
Test respiratoire à l’urée – Helicobacter pylori
Test non invasif et très précis pour dépister la bactérie responsable : des gastrites chroniques…
Détail




Pourquoi nous choisir ?
Une équipe dédiée à votre santé
✔ Expertise médicale
Analyses réalisées et supervisées par une médecin biologiste expérimentée.
✔ Technologie de pointe
Équipements modernes garantissant des résultats fiables et rapides.
✔ Analyses complètes
Du bilan général aux examens spécialisés (fertilité, hormonologie, PCR, génétique…).
✔ Confidentialité & sécurité
Protection totale de vos données et de vos résultats.
✔ Accompagnement personnalisé
Écoute, conseils clairs et suivi adapté à chaque patient.
✔ Emplacement central
Laboratoire situé à Guéliz, facilement accessible.
- la bactériologie
- la virologie
- l’immunologie
- la biologie de reproduction
- l’hématologie
- la parasitologie et la mycologie

Années d'expérience

Patients satisfaits
Nos dernières actualités
- 12 octobre 2022
- eureka
Des réductions pour une inspection complète Dans notre laboratoire.
Lorem ipsum dolor sit amet, consectetur adipiscing elit. Phasellus ut nisl ultrices, ultrices arcu sed, sollicitudin tellus. Curabitur…
- 11 septembre 2022
- eureka
Les dossiers médicaux sont en sécurité de nos jours.
Lorem ipsum dolor sit amet, consectetur adipiscing elit. Phasellus ut nisl ultrices, ultrices arcu sed, sollicitudin tellus. Curabitur…
- 10 août 2022
- eureka
rapide et sécurisé pour vous
Lorem ipsum dolor sit amet, consectetur adipiscing elit. Phasellus ut nisl ultrices, ultrices arcu sed, sollicitudin tellus. Curabitur…





